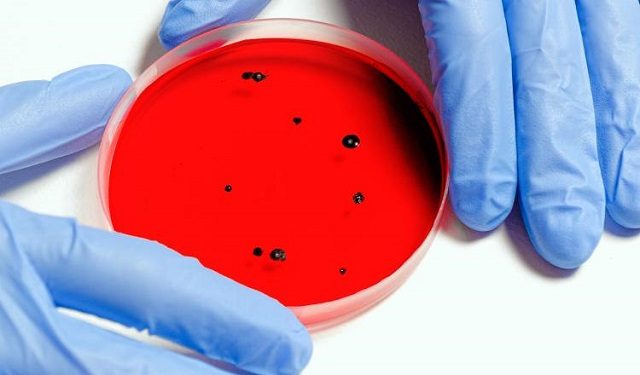

PANAMÁ
Superbacterias: ¿Cómo protegerse?
- Redacción
- /
- ey@epasa.com
- /
- @panamaamerica
Algunas de estas bacterias pueden causar neumonía.
Se estudia cómo prevenir la resistencia a los antimicrobianos. Foto: Ilustrativa / Pexels
¿Sabe qué son las superbacterias? Ellas son cepas de bacterias, virus, parásitos y hongos que son resistentes a la mayoría de los antibióticos y otros medicamentos que se utilizan comúnmente para tratar las infecciones que causan.
Algunos ejemplos de superbacterias incluyen bacterias resistentes que pueden causar neumonía, infecciones de las vías urinarias e infecciones de la piel.
La resistencia a los medicamentos y la resistencia a los antimicrobianos, es un fenómeno natural que puede ralentizarse, pero no detenerse. Con el tiempo, los gérmenes como las bacterias, los virus, los parásitos y los hongos se adaptan a los medicamentos que están diseñados para matarlos y cambian para asegurar su supervivencia, indica el Dr. Pritish K. Tosh de Mayo Clinic.
Esto hace que los tratamientos anteriormente estándar para algunas infecciones sean menos eficaces y a veces ineficaces. Aunado a ello, los investigadores continúan evaluando cómo estos gérmenes desarrollan resistencia. Además, se estudia cómo diagnosticar, tratar y prevenir la resistencia a los antimicrobianos.
El uso de antibióticos de forma indebida, tener prácticas deficientes de prevención y control de infecciones, vivir o trabajar en condiciones sucias y manipular incorrectamente los alimentos, puede intensificar la aparición y propagación de gérmenes resistentes a los antimicrobianos.
En este sentido, para protegerse de los gérmenes nocivos y reducir el riesgo de enfermedades, pueden hacer lo siguiente:
- Lávase las manos a menudo con agua y jabón o usa un desinfectante de manos a base de alcohol.'
La resistencia a los medicamentos es un fenómeno natural que puede ralentizarse, pero no detenerse.
Los investigadores continúan evaluando cómo estos gérmenes desarrollan resistencia a los medicamentos.
- Maneje los alimentos adecuadamente, por ejemplo, separa los alimentos crudos de los cocidos, cocine bien los alimentos y use agua limpia.
VEA TAMBIÉN: María Celeste Arrarás: El programa de la periodista supera el millón de visitas en YouTube
- Evite el contacto cercano con personas que estén enfermas.
- Asegúrese de que sus vacunas estén al día.
Adicional, para ayudar a enfrentar la resistencia a los antibióticos es necesario usar los antibióticos según las instrucciones y solo cuando sea necesario; completar los tratamientos, incluso si se sienten mejor; no comparta los antibióticos con otros y no use los medicamentos recetados sobrantes.
¡Mira lo que tiene nuestro canal de Youtube!



Para comentar debes registrarte y completar los datos generales.